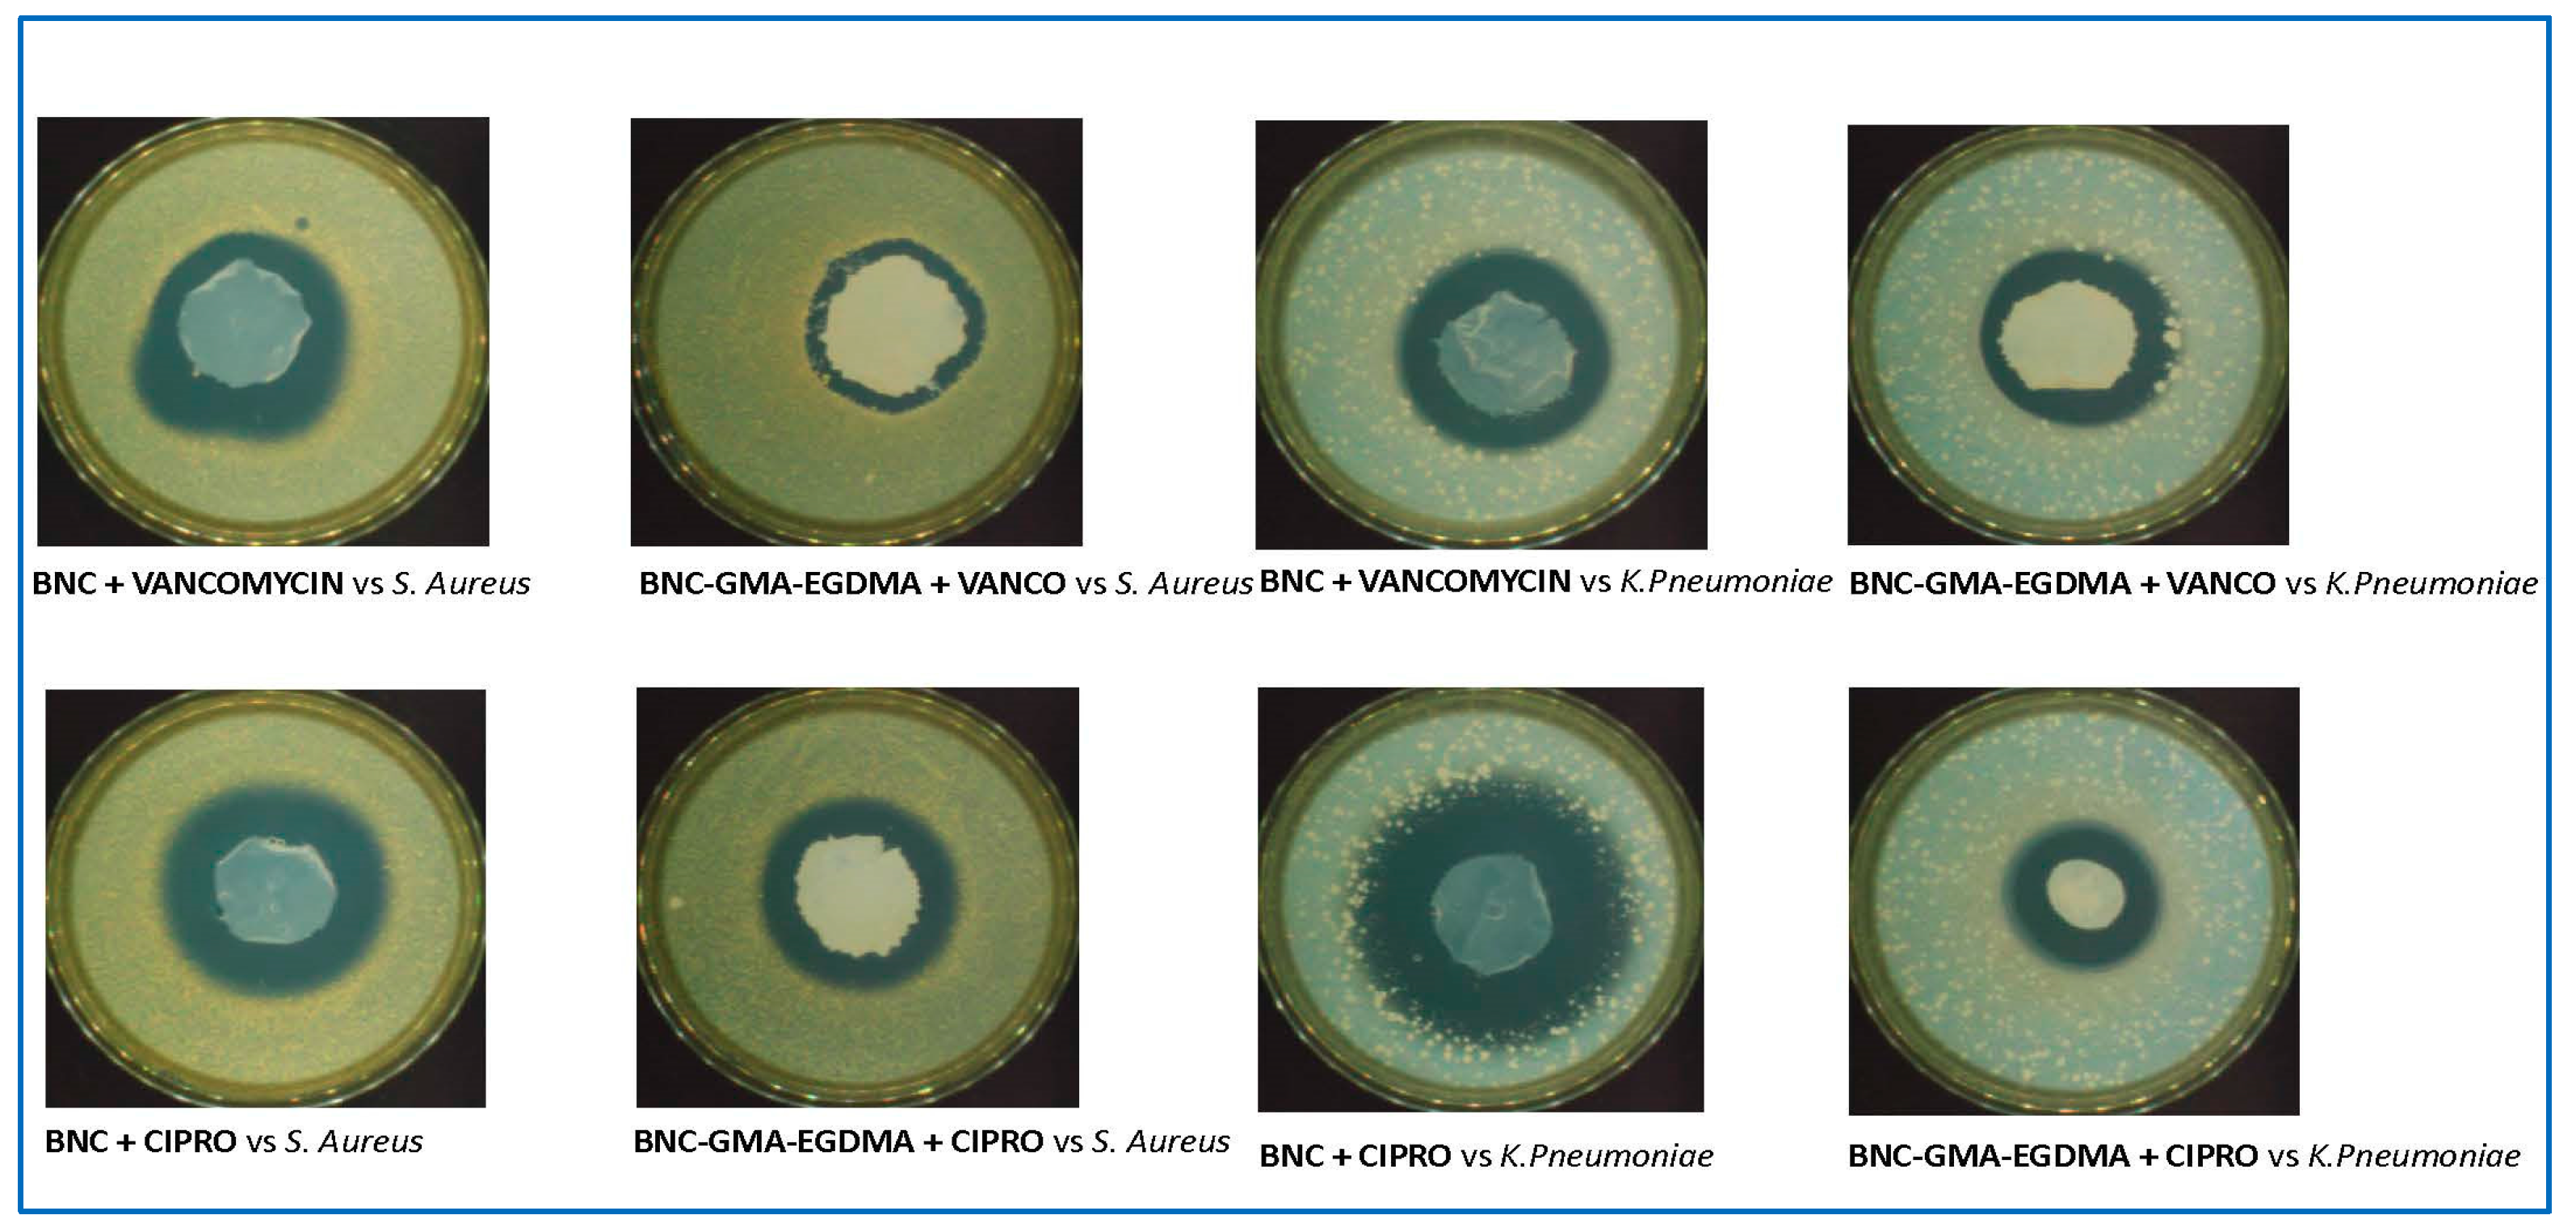
Nanomaterials 09 01668 g021 550

1. Introduction
Nanocelluloses (NCs), namely cellulose-based materials with peculiar physicochemical properties, appear as a new option offering a wide range of specific applications quite different from cellulose. Nanocellulose-based biomaterials have been significantly investigated for biomedical applications due to their excellent physical and biological properties like biocompatibility and low cytotoxicity [
1].
A nanocellulose that has been studied in recent years is bacterial nanocellulose (BNC), a nanofibrilar polymer produced by several species of bacteria [
2]. BNC is a hydrogel containing 1% of nanocellulose. It cannot be ignored by researchers interested in nanocellulose due to its unique properties, such as chemical purity, biocompatibility, inertness and non-toxicity, biofunctionality and hypoalergenicity, good mechanical strength, high absorbency, and the possibility of forming any shape and size. Due to its properties, the study and use of BNC are focused on biomedicine. Tissue engineering has been associated with BNC mostly because of its low cytotoxicity, high porosity, biocompatibility, and non-resorbability [
1]. For soft-tissue implants and cartilage replacements, the fibrillar network of BNC offers high tensile mechanical properties and a hydrogel-like behaviour as BNC interacts with the surrounding water medium. However, despite recent advances, there are still many challenges to overcome before the full potential of BNC can be completely realized as a choice of material in tissue-engineering applications. Different physical modification, i.e., modification to change porosities, crystallinities, and fibre densities, and chemical modifications, i.e., modification of the chemical structures and functionalities, have been investigated to enhance BNC properties suitable for its applications in tissue-engineering applications [
3].
In the recent review on nanocellulose as a natural source for groundbreaking applications in materials science, BNC’s future has been widely discussed [
4]. The key problems seem to be BNC bioreactor designs and implant production costs. Economic considerations related to different applications must be taken into account: a high-price implant material, for example, in a first artificial heart bypass, can be more competitive than a Nata de Coco-based food thickener obtained in mass production. The conclusion of authors of reference [
4] is that nowadays there are no standard answers regarding BNC production costs. Noteworthy, some BNC-based medical products are on the market and are Food and Drug Administration (FDA) approved and European Community (CE) -certified.
Besides the efforts dedicated to the advancement in production technologies and the estimation of various pitfalls associated with BNC production, a more scientific question is intriguing, if BNC and its composites with other polymers/nanoparticles can become the material of preference in current regenerative medicine, starting from biomedical applications of BNC and functionalized BNC in drug delivery, tissue engineering and antimicrobial wound healing [
5]. A very recent paper stating the BNC haemocompatibility favours developing BNC biomedical applications [
6]. Furthermore, from a chemical point of view, BNC is chemically identical with plant cellulose but is free of byproducts like lignin, pectin, and hemicelluloses, featuring a unique reticulate network of fine fibres and these are physicochemical peculiarities that make the difference between BNC and other nanocellulose materials [
7]. BNC has been already been proposed as a skin-tissue repair material in vivo to replace conventional gauze dressings. According to the results of many studies in the field of wound healing, BNC has been shown to be a superior candidate for conventional wound-dressing materials [
8]. For tissue engineering and wound healing, the problems of infection and inflammation have to be carefully considered as BNC does not possess any antimicrobial or anti-inflammatory characteristics. BNC can be endowed with antimicrobial or anti-inflammatory activities by drug loading. Drug loading in BNC-based carriers includes physical absorption/adsorption and chemical conjugation [
9]. BNC hydrogels can be fabricated using as low as 1% nanocelluloses, which may benefit from a large water content, that allows for the drugs to be loaded via diffusion and adsorption; however, the downside of this process is the prolonged loading time, which is not practical for clinical or industrial purposes. The loading time is a minimum 24 h and can reach 48 h. As the amount of the loaded drug is evaluated by the release experiments it is difficult to measure the real adsorbed amount.
Anyway, the most common loading method involves the immersion of the BNC delivery system in the drug solution. For example, BNC has been saturated with the antibiotic fusidic acid [
10] and tetracycline hydrochloride has been loaded on bacterial cellulose composite membranes for controlled release [
11]. BNC can be addressed for the delivery of a broad range of bioactive cargos [
9]. The antiseptic octenidine has been used to provide active wound dressings based on bacterial nanocellulose [
12]. The behaviour of BNC membranes has been studied as systems for topical delivery of lidocaine, an anaesthetic drug with high solubility in water in the form of hydrochloride and commonly used in surgery and topical application [
13].
Since 2009 a review described the design and applications of biodegradable cellulose-based hydrogels and suggested that cellulose-based hydrogels, including BNC, could be ideal platforms for the design of scaffolding biomaterials in the field of tissue engineering and regenerative medicine [
14]. The advantage of BNC is that it is obtained by a strain directly in the hydrogel status. Hydrogel-based devices have been developed for controlled drug delivery.
The aim of this study is to provide bioactive BNCs in the form of hydrogel, suitable for tissue engineering, regenerative medicine and wound dressing. We focus our attention on modified BNCs, in particular grafted and cross-linked BNC, made bioactive by loading drugs. The study concerns also the loading of BNC as it is and the comparison between BNC and modified BNC. The modifications were pursued by grafting glycidylmethacrylate (GMA) and cross-linking with ethylene glycol dimethacrylate (EGDMA). GMA-grafted and EGDMA-cross-linked BNCs of peculiar chemical and mechanical properties were obtained by a surface modification that maintained the original network structure of BNC. As concerns this last aspect, our study can be positioned in a relationship with BNC nanocomposites processing techniques that allow the incorporation of functional nanoreinforcements, nanofillers and additional phases without disturbing the original network structure of BNC [
15]. The choice of GMA was justified by previous results that stated that GMA appendages endow cellulose with new properties due to the surface GMA network formation that acts like a molecular sponge [
16]. GMA insertion is a radical-based process that was investigated in term of mechanism, detailed in all the synthetic aspects and huge supported by different characterisation techniques. Cellulose maintained its peculiar properties, as the methodology to insert GMA did not induce a coating by avoiding its polymerisation. GMA-modified cellulose was defined as a multitasking material as it found applications in quite different fields [
16]. The adsorption and release properties of antibiotics is strictly related to the aim of this paper [
17]. GMA-grafted fabrics loaded with vancomycin and other antibiotics were developed for topic antibacterial activity [
18]. For BNC modification, GMA was also associated to EGDMA, a very efficient cross-linking agent already tested on nanocellulose [
19] and on imprinted hydrogel prepared from
N,
N-dimethylacrylamide and tris(trimethylsiloxy)sililpropyl methacrylate as the main components, methacrylic acid as functional monomer [
20]. The idea of using EGDMA comes not only from the need to reinforce BNC, but also from the hope that GMA and EGDMA can act in synergy in holding drugs. BNC and GMA-grafted and EGDMA-cross-linked BNCs were made bioactive by loading the antibiotics vancomycin and ciprofloxacin. Vancomycin is a glycopeptide antibiotic used in the treatment of infections caused by Gram-positive bacteria, such as
Staphylococcus aureus. Vancomycin has been found many applications for bone regeneration. Notably, it does not interfere with normal in vivo bone regeneration [
21]. It has also been selected as an antibiotic drug for enhanced bone regeneration [
22]. Finally vancomycin has been used as polyhydroxy antibiotic for bio-inspired cross-linking and matrix–drug interactions for advanced wound dressings with long-term antimicrobial activity [
23]. The broad-spectrum antibiotic ciprofloxacin has been used as model drug for BCN-cyclodextrin adduct to form drug-nanocarrier systems [
24].
2. Materials and Methods
Hydrogen peroxide (H2O2) solution 30% (w/w), glycidyl methacrylate (GMA), ethylene glycol dimethacrylate (EGDM), iron sulfate heptahydrate (FeSO4∙7H2O), sodium hydroxide (NaOH), hydrochloric acid (HCl, 36.0–38.0% in water) and corn step liquor were purchased from Sigma Aldrich (St. Louis, MO, USA). Gluconacetobacter xylinus (ATCC 10245) was purchased from the American Type Culture Collection (ATCC, Manassas, VA, USA).
2.1. Synthesis of Bacterial Nanocellulose (BNC)
BNC was obtained by the use of the bacterium Gluconacetobacter xylinus (ATCC 10245). The microorganism was inoculated in 5 mL ATCC medium 1 (5 g/L yeast extract, 3 g/L peptone, 25 g/L mannitol) and grown at 26 °C under static conditions for 48 h. An aliquot of 1 mL of this culture was transferred in a 250 mL Erlenmeyer flask containing 40 mL of corn steep liquor (CSL)-glucose medium (26 g/L CSL, 20 g/L glucose, 2.7 g/L Na2HPO4, 1.15 g/L citric acid monohydrate). The inoculated flasks were incubated at 30 °C for 144 h under static conditions. The BNC disk was removed from the medium and washed exhaustively with distilled water. Overnight treatment with 70 mL NaOH 1M followed by washing with water until neutral pH bleached the BNC sample. The final weight was 2.56 g.
2.2. Grafting of BNC
BNC was put in a three-neck round-bottom flask equipped with a thermometer and a condenser, containing 25 mL water for 1 g of BNC, reaction scale and reagent amount being reported in
Table 1 and
Table 2. The suspension was maintained under mechanic stirring at 80 °C for 30 min. H
2O
2 and FeSO
4 (Fenton reagent) were added and left activating cellulose for 1 h at 80 °C. GMA was dropped in the flask and left to react for 30 min. BNC was filtered using a Gooch funnel and exhaustively washed with water at room temperature and with water at 45 °C to remove residual inorganic and organic reagents. The washed BNC was stored at 8 °C.
2.3. Grafting and Cross-Linking of BNC
BNC was put in a three-neck round-bottom flask equipped with a thermometer and a condenser, containing 50 mL water for 2.2 g of BNC, reaction scale and reagent amount being reported in
Table 3. The suspension was maintained under mechanical stirring at 80 °C for 30 min. H
2O
2 and FeSO
4 (Fenton reagent) and left activating cellulose for 1 h at 80 °C. GMA and EGDMA were simultaneously dropped in the flask and left reacting for 30 min. BNC was filtered using a Gooch funnel and exhaustively washed with water at room temperature and with water at 45 °C to remove residual inorganic and organic reagents. The washed BNC was stored at 8 °C.
2.4. Fourier Transform Infrared (FT–IR) Spectroscopy Analysis
The solid phase Fourier transform infrared (FT–IR) spectra of the powdered sample, obtained by BNC lyophilization and mixed with infrared-grade KBr, were generated using an ALPHA spectrometer (Bruker, Bremen, Germany). Data were analyzed using OPUS software, version 7.0 (Bruker, Bremen, Germany). The acquisition of the spectra were performed in the range 4000–400 cm
−1. The estimation of average molar substitution ratio (MS) was obtained with the method used in our previous works, Equation (1) [
16,
25]:
At least two tests were carried out to assure reproducibility and accuracy for the integration calculations.
2.5. Solid-State Cross-Polarization Magic-Angle Spinning (CP-MAS) 13C Nuclear Magnetic Resonance (NMR)
The 13C nuclear magnetic resonance (NMR) analysis was performed by using a dipolar decoupling cross-polarization magic-angle spinning (DD-CP-MAS) technique with a Bruker Avance 300 spectrometer (75.47 MHz, Bruker, Milano, Italy). Concerning data acquisition parameters: the repetition time (D1) was equal to 8 s, while the contact time and the spin rate were 2 ms and 1000 Hz, respectively. 2 K scans were collected to obtain good quality spectra. The samples were positioned in a zirconium rotor (diameter: 4 mm; height: 21 mm). Tetramethylsilane was the reference substance for the chemical shifts. Benzene was used as secondary reference standard.
The crystallinity index (Cr. I %) of BNC materials was evaluated by means of Equation (2) [
16,
25].
A corresponds to integrals of the C-4 peaks at 86–92 ppm (crystalline) and
B to the integrals of the C-4 peaks at 80–86 ppm (amorphous).
2.6. Scanning Electron Microscopy (SEM) Experiments
Scanning electron microscopy (SEM) micrographs of the film surfaces were obtained on a Zeiss EVO 50 microscope (Zeiss, New York, NY, USA), equipped with a LaB
6 electron gun and operating at 15 kV. SEM was used to measure BNC fibre diameters and to study their morphologies. Prior to the SEM observation, a few nanometers gold film was deposited onto the sample surface in order to avoid a charging effect during SEM testing. The BNC fibers diameters statistical distributions were obtained analyzing the SEM micrographs with ImageJ (version 1.52r, NIH, National Institutes of Health, Bethesda, MD, USA) software [
26], collecting more than 300 diameter sizes for each specimen.
2.7. Mechanical Properties
The structure and the properties of BNC strongly depend on the choice of the cellulose forming bacterial strain. The tensile strength changes significantly, too. For
Gluconacetobacter xylinus ATCC 10245 the tensile strength is reported 0.184 mPa ([
2], p. 185). Tensile strength and elongation to failure of BNC samples of 2 cm length, 0.5 cm width and 0.5 thickness were measured with a Dynamic Mechanical Analyzer (model DMA Q800, TA instruments, Milano, Italy). Samples were air dried for 2 h, with a water reduction content of the 50%. The compression reduced the water content of the 80%.
2.8. Adsorption and Release Experiments
Aqueous solutions of vancomycin (VC) and ciprofloxacin (CP), having a concentration 2 × 10−3 M were prepared. The CP solution was at pH = 3 with HCl 0.02 N to solubilize CP. BNCs (1.5 g, solid nanocellulose content 15 mg) were put into contact with the drug solution (25 mL). The flask was shaken in a thermostatic bath Julabo at 25 °C, (model SW22, 100 rpm, JULABO GmbH, Seelbach, Germany) for 24 h to get the equilibrium. Adsorption solutions were analyzed at different times with an ultraviolet (UV) spectrophotometer. Loaded BNCs were submitted to release experiments by removing the BNC from the adsorption solution and transferring it into a flask with deionized pure water (25 mL). The amount of loaded drug release was evaluated by submitting at different times the release solution to UV spectrophotometry.
2.9. Ultraviolet (UV) Spectroscopy Analysis
The amount of adsorbed/released molecules over time was monitored through quantitative ultraviolet–visible (UV–Vis) analysis (UV-spectrophotometer JASCO V-650; Jasco Europe, Cremella LC, Italy), Spectra ManagerTM software (version II, Jasco Europe, Cremella LC, Italy). Several aliquots of drug solution were collected at different times and submitted to UV acquisition. The acquisition wavelength range was set from 500 to 240 nm. The absorbance values of VC peak at λmax = 280 nm and CP peak at λmax = 272 nm were converted in concentration by using previously created calibration curves.
2.10. Antibacterial Activity Tests
The tests were run according to UNIEN ISO 20645:2005 by Centrocot (
www.centrocot.it).
Staphylococcus aureus (ATCC 6538 LOT: DSM 799-0415) and
Klebsiella pneumoniae (ATCC 4352 LOT: DSM 789-0513) were cultured in Triptone and Soya medium for 24 h at 37 °C. The suspensions obtained were diluted to 10
8 UFC/mL. 1 mL samples (10
8 UFC/mL) were added to 150 mL of Triptone Soya Agar (LOT: Oxoid 1837431) at 45 °C to afford culture medium. A BNC sample of size 25 ± 5 mm was incubated in 5 mL of the culture medium for 24 h at 37 °C. The test was repeated on four equal BNC samples. Reference material was 100% cotton fabric according to International Organization for Standardization (ISO) 105/F02:2009.
4. Discussion
The study presented in this paper can be considered the first step towards a platform of new biomaterial based on BNC, built up with a method that was not yet investigated for nanocellulose. The results obtained with these studies start from the real possibility of applying to nanocellulose a process that was extensively studied for cellulose [
16]. The peculiarity of this process is that it adds new properties to cellulose without modifying the original ones. The explanation for these results is the mechanism that involves two steps; the first is the generation by hydrogen abstraction of carbon centred macroradicals, sterically hindered and for this reason particularly stable. According to the polar effects involving in selective radical trapping process, these nucleophilic radicals are quickly trapped by double bonds substituted by electron withdrawing groups. Methacrylate groups are the ideal scavengers. The results of the scavenging process are the formation of a very stable C–C bond, and the maintenance of the glucose structure in the cellulose polymers that guaranties the maintenance of the cellulose properties. If many radicals are formed as the same time by a high reactive and unselective radical like OH
. generated by a Fenton-type process, the scavenging step endows the cellulose surface of a network of methacrylate residues that is capable of capturing molecules like a sponge [
16]. In collaboration with clinics of the Humanitas Hospital in Rozzano, Milano, Italy, we demonstrated that polysaccharide materials derivatised with GMA and loaded with antibiotics have topic antibacterial activity [
17,
18]. The clinics made in vitro and ex-vivo tests that stated the compatibility of GMA modified gauze with biological medium and with human skin. These results support the hypothesis that the same modification on nanocellulose leads to biocompatible materials. On the other hand the biocompatibility of BNC is well-established [
6] and nanocellulose materials have been recently critically reviewed for drug delivery [
27]. In particular they have shown considerable potential for developing a novel generation of controlled drug delivery for different routes of administration (oral, transdermal, etc.).
The transfer of this process to BNC was satisfying. As for the grafting on cellulose, the temperature is crucial in the first step in order to maintain the radical chain, as Fe(II) is used in catalytic amount and needs to be regenerated, and also in the second step to solubilize the methacrylate monomers in water. Entry 6 in
Table 1 shows that the temperature cannot be reduced from 80 °C to 60 °C even with high reagents amounts. The Fenton-type process on BNC was successfully expanded to EGDMA, affording cross-linking that was not studied on cellulose. The cross-linking was finalised to enhance the resistance of BNC and to form on BNC a network with GMA of high loading capability and of long-term antibacterial property. The main drawback is the homogeneity when the starting BNC is of the order of magnitude of more than 2 g, due to the difficulties of efficient stirring. Future research directions will be the design of a suitable device to guarantee homogeneity, scale up, and economic evaluations of the process.
It is well-known that the properties of hydrogel state appear to be absolutely suitable to develop biomaterial in biomedical applications. The purpose of this study was to use both BNC and modified BNC in the hydrogel form. By contrast with many studies on BNC, we decided not to dry and rehydrate the samples, to reduce the step numbers to reach the final products. The percentage of nanocellulose in our modified BNCs increased in agreement with the MS, but our modified BNCs remained in the hydrogel state if the grafting and cross-linking reaction conditions were carefully controlled to not overcome MS = 1. At high MS, modified BNC became quite solid, due to water elimination that reached the 50%. Solid modified BNCs are not the achievement of this study, but they could be further developed as solid functionalised nanocelluloses of high purity.
SEM images and mechanical tests we presented cannot be compared with literature data that are mainly produced on dry samples. However mechanical tests of our modified BNC are very encouraging with respect to BNC as it is, in terms of resistance to the stress and strain. As expected, the cross-linking in particular has a positive effect on mechanical resistance, supporting the aim of our studies to make BNC cross-linked. SEM images are very interesting as it seems that GMA alone forms a dense thick network, while GMA-EGDMA network appears less dense. The density of the GMA network certainly helps the drug to be captured. GMA-EGDMA network is less dense, but due to the cross-linking is more rigid. This could induce a more stable electrostatic interaction between the GMA appendages and the drug. From a thermodynamic point of view we could argue that the loading enthalpy factors are more favourable for GMA entrapped in the cross-linking than for mobile GMA residues. At the same time, the BNC network was maintained. The observed pseudo-spherical structures could be explained by the formation of small pieces of cotton. It will be necessary to reconsider starting BNC preparation to avoid them.
It is very intriguing to comment on the crystallinity of the modified BNC that is maintained also at high MS equal to the BNC as it is. This behaviour confirms that the Fenton-type process we developed respects the morphology not only for cellulose, but also for nanocellulose. However, in our opinion the mechanism is not exactly the same. In the case of cellulose the functionalization occurs on the surface and in the bulk, while in the case of BNC it occurs on the fibre surface and does not modify at all the fibre itself.
To make the BNC bioactive we decided to use real antibiotics, with the idea that although antibiotics can develop resistance, they are the most potent tools we have to fight against infection. Hospital infections, surgical complications infections and wound infections are a tremendous problem for all of us and represent a relevant social cost, too.
BNC as it is appears suitable to host antibiotics like VC and CP, whose activities are well-established. VS is especially important in its use in the hospital.
Modified BNCs loaded with VC and CP can be developed as antibacterial materials. This conclusion is supported not only by adsorption release data collected in the laboratory, but also by the antibacterial activities tests entrusted to the expert Centrocot staff that use two very dangerous bacteria like S.A. and K.P. BNC-GMA and BNC-GMA-EGDMA are not as available as BNC. However their properties justify the effort to prepare them. First of all, the mechanical properties are relevant. GMA appendages alone and associated with EGDMA cross-linking are capable of enhancing the BNC resistance. But likewise important is their interaction with the antibiotics. Efficient loading and holding depend on MS. BNC-GMA are efficient in the loading and holding of VC and CP, similarly to GMA modified cellulose. The only cross-linking with EGDMA does not seem efficient enough to hold drugs. The grafting and cross-linking are responsible for the most efficient holding capability. BNC-GMA-EGDMA behaviour suggests that there is a synergy of EGDMA and GMA to efficiently hold the drug. The synergy of EGDMA and GMA can be interpreted in the sense that GMA appendages create a network on a single cellulose chain and that EGDMA creates a network among different cellulose chains. Thus, BNC-GMA and BNC-GMA-EGDMA could open the way to a new kind of BNC, suitable to modulate the drug-delivery phenomenon in biomedical applications.